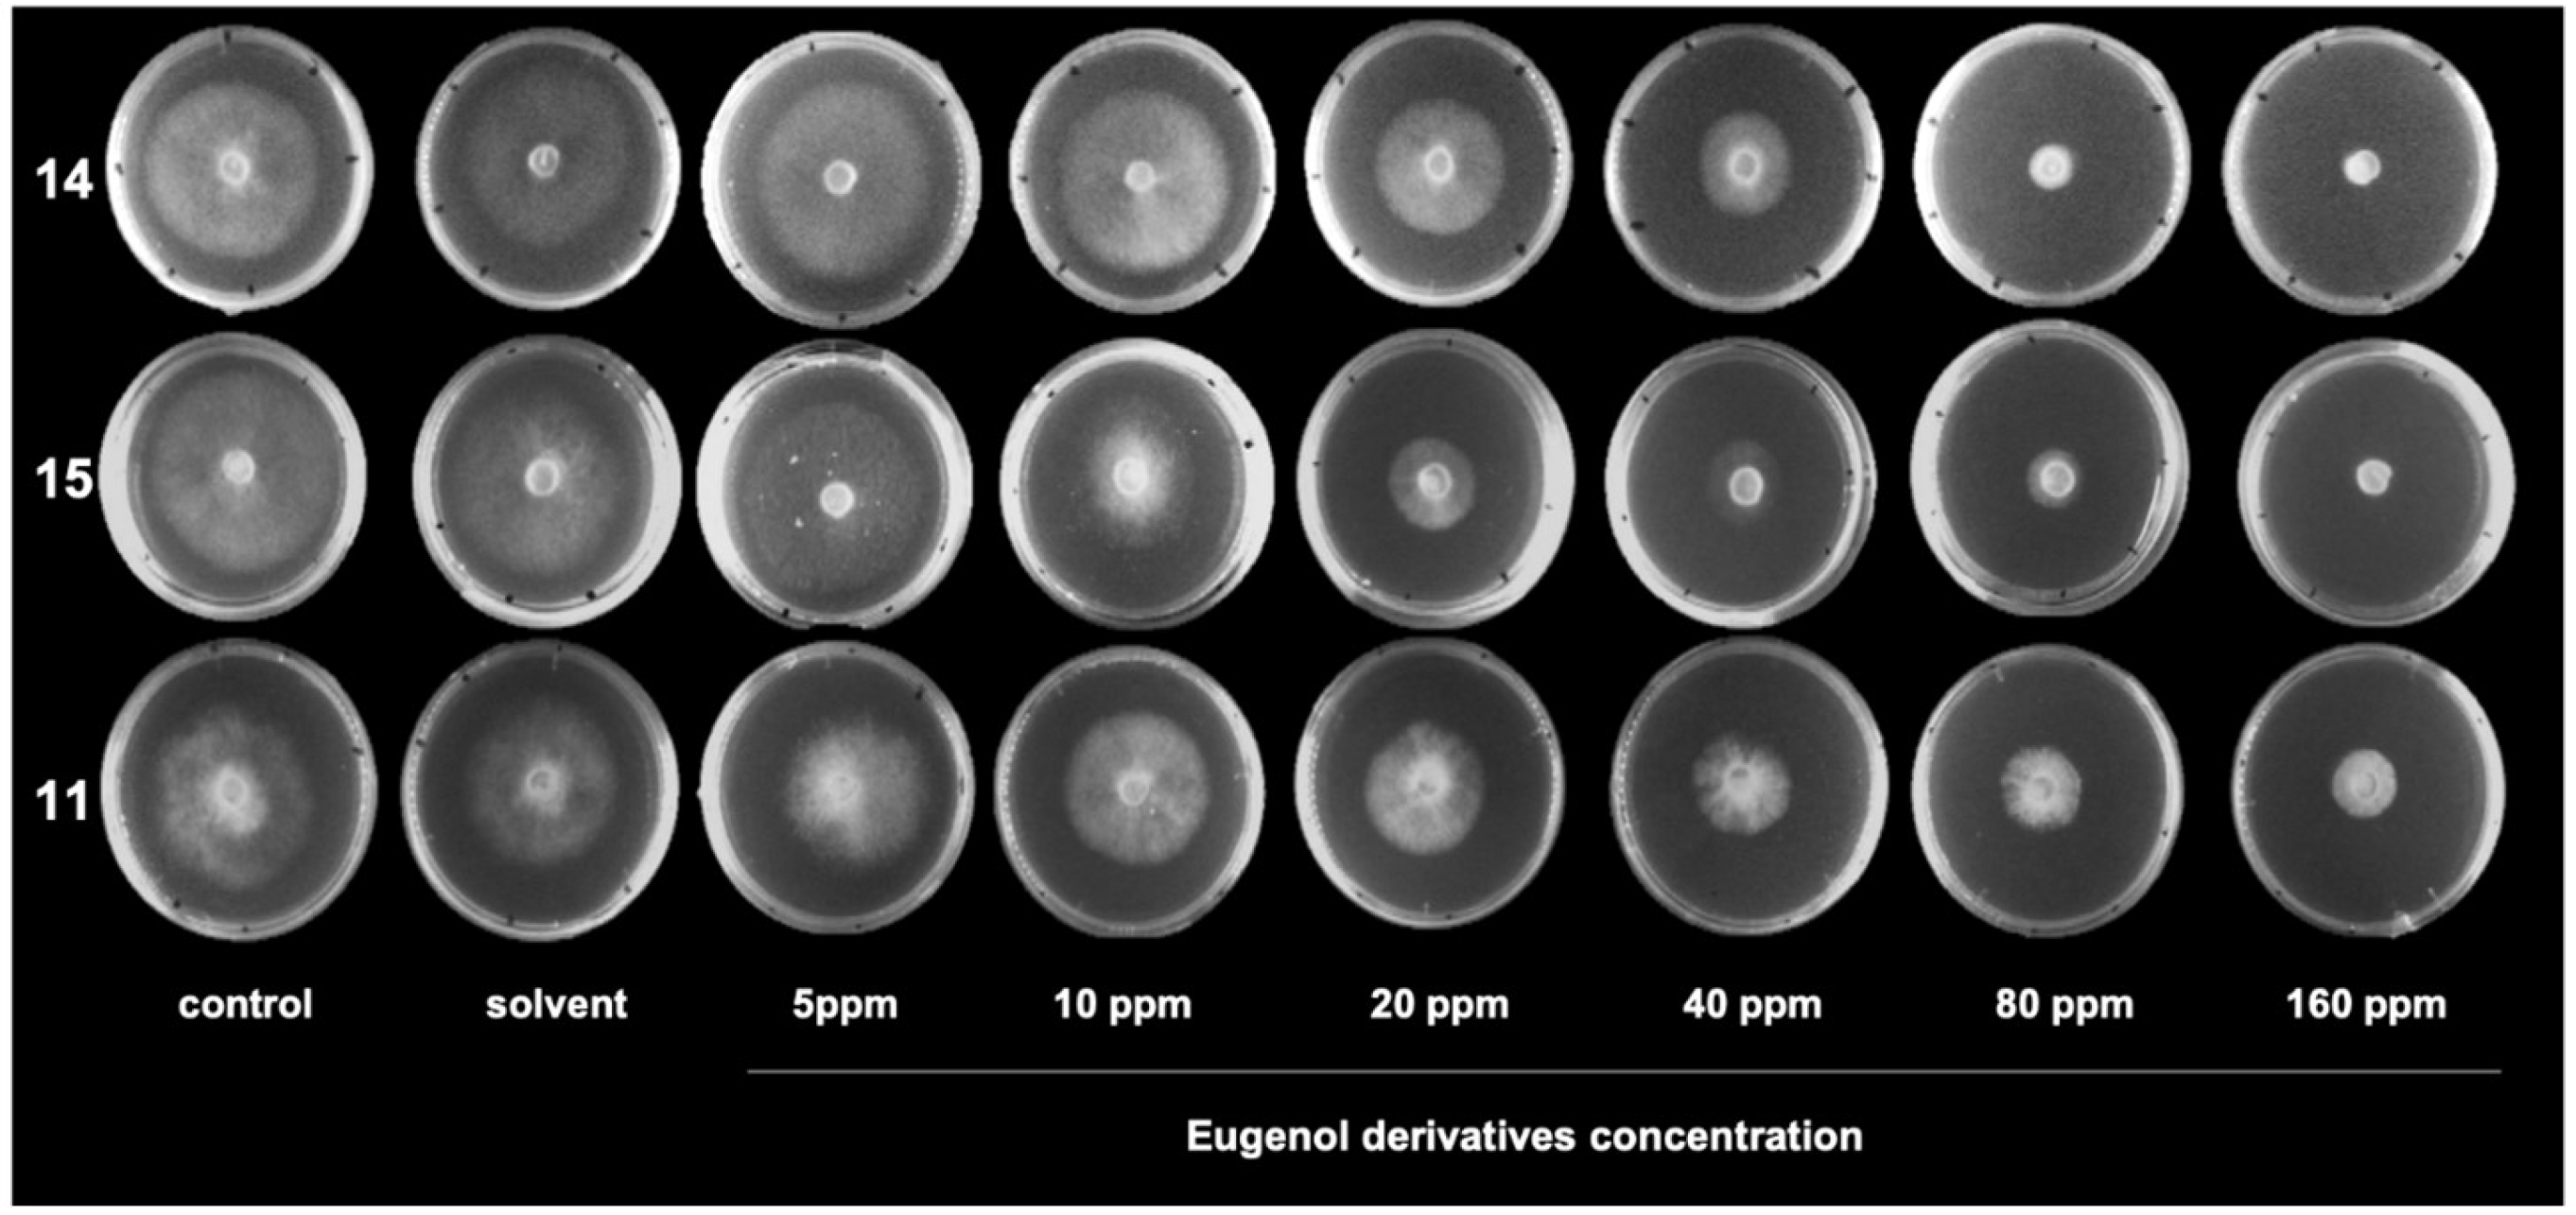
Molecules 24 01239 g004 Molecules 24 01239 g004

Antifungal Activity of Eugenol Derivatives against Botrytis Cinerea
Abstract
1. Introduction
2. Results
Evaluation of Antifungal Activity of Eugenol and Eugenol Derivatives on Botrytis cinerea
3. Discussion
4. Materials and Methods
4.1. Chemistry
4.2. Synthesis
General Procedures
4.3. Biological Assays
4.3.1. B. cinerea Isolates
4.3.2. Effect of Eugenol Derivatives on Mycelial Growth of B. cinerea in Solid Media
4.3.3. Effect of Eugenol and its Derivatives on ROS Production by Botrytis cinerea
5. Conclusions
Author Contributions
Funding
Acknowledgments
Conflicts of Interest
References
- Romanazzi, G.; Droby, S. Control Strategies for Postharvest Grey Mould on Fruit Crops. In Botrytis—The Fungus, the Pathogen and Its Management in Agricultural Systems; Fillinger, S., Elad, Y., Eds.; Springer: Berlin/Heidelberg, Germany, 2016; pp. 217–228. [Google Scholar]
- Fillinger, S.; Elad, Y. Chemical Control and Resistance Management of Botrytis Diseases; Springer International Publishing: Cham, Switzerland, 2016. [Google Scholar]
- Esterio, M.; Munoz, G.; Ramos, C.; Cofre, G.; Estevez, R.; Salinas, A.; Auger, J. Characterization of Botrytis cinerea Isolates Present in Thompson Seedless Table Grapes in the Central Valley of Chile. Plant Dis. 2011, 95, 683–690. [Google Scholar] [CrossRef] [PubMed]
- Grayer, R.J.; Harborne, J.B. A Survey of Antifungal Compounds from Higher-Plants, 1982–1993. Phytochemistry 1994, 37, 19–42. [Google Scholar] [CrossRef]
- Grayer, R.J.; Kokubun, T. Plant-fungal interactions: The search for phytoalexins and other antifungal compounds from higher plants. Phytochemistry 2001, 56, 253–263. [Google Scholar] [CrossRef]
- Caruso, F.; Mendoza, L.; Castro, P.; Cotoras, M.; Aguirre, M.; Matsuhiro, B.; Isaacs, M.; Rossi, M.; Viglianti, A.; Antonioletti, R. Antifungal Activity of Resveratrol against Botrytis cinerea Is Improved Using 2-Furyl Derivatives. PLoS ONE 2011, 6, e25421. [Google Scholar] [CrossRef]
- Saiz-Urra, L.; Racero, J.C.; Macias-Sanchez, A.J.; Hernandez-Galan, R.; Hanson, J.R.; Perez-Gonzalez, M.; Collado, I.G. Synthesis and Quantitative Structure-Antifungal Activity Relationships of Clovane Derivatives against Botrytis cinerea. J. Agric. Food Chem. 2009, 57, 2420–2428. [Google Scholar] [CrossRef]
- Chung, G.; Im, S.T.; Kim, Y.H.; Jung, S.J.; Rhyu, M.R.; Oh, S.B. Activation of transient receptor potential ankyrin 1 by eugenol. Neuroscience 2014, 261, 153–160. [Google Scholar] [CrossRef]
- Daniel, A.N.; Sartoretto, S.M.; Schmidt, G.; Caparroz-Assef, S.M.; Bersani-Amado, C.A.; Cuman, R.K.N. Anti-inflammatory and antinociceptive activities of eugenol essential oil in experimental animal models. Braz. J. Pharmacogn. 2009, 19, 212–217. [Google Scholar] [CrossRef]
- Ali, S.M.; Khan, A.A.; Ahmed, I.; Musaddiq, M.; Ahmed, K.S.; Polasa, H.; Rao, L.V.; Habibullah, C.M.; Sechi, L.A.; Ahmed, N. Antimicrobial activities of Eugenol and Cinnamaldehyde against the human gastric pathogen Helicobacter pylori. Ann. Clin. Microbiol. Antimicrob. 2005, 4, 20. [Google Scholar] [CrossRef]
- Saeed, S.; Tariq, P. In vitro antibacterial activity of clove against gram negative bacteria. Pak. J. Bot. 2008, 40, 2157–2160. [Google Scholar]
- Park, M.J.; Gwak, K.S.; Yang, I.; Choi, W.S.; Jo, H.J.; Chang, J.W.; Jeung, E.B.; Choi, I.G. Antifungal activities of the essential oils in Syzygium aromaticum (L.) Merr. Et Perry and Leptospermum petersonii bailey and their constituents against various dermatophytes. J. Microbiol. 2007, 45, 460–465. [Google Scholar] [PubMed]
- Pinto, E.; Vale-Silva, L.; Cavaleiro, C.; Salgueiro, L. Antifungal activity of the clove essential oil from Syzygium aromaticum on Candida, Aspergillus and dermatophyte species. J. Med. Microbiol. 2009, 58, 1454–1462. [Google Scholar] [CrossRef] [PubMed]
- Ogata, M.; Hoshi, M.; Urano, S.; Endo, T. Antioxidant activity of eugenol and related monomeric and dimeric compounds. Chem. Pharm. Bull. 2000, 48, 1467–1469. [Google Scholar] [CrossRef]
- Yang, Y.C.; Lee, S.H.; Lee, W.J.; Choi, D.H.; Ahn, Y.J. Ovicidal and adulticidal effects of Eugenia caryophyllata bud and leaf oil compounds on Pediculus capitis. J. Agric. Food Chem. 2003, 51, 4884–4888. [Google Scholar] [CrossRef] [PubMed]
- Zheng, G.Q.; Kenney, P.M.; Lam, L.K.T. Sesquiterpenes from clove (eugenia caryophyllata) as potential anticarcinogenic agents. J. Nat. Prod. 1992, 55, 999–1003. [Google Scholar] [CrossRef] [PubMed]
- Pramod, K.; Ansari, S.H.; Ali, J. Eugenol: A natural compound with versatile pharmacological actions. Nat. Prod. Commun. 2010, 5, 1999–2006. [Google Scholar] [CrossRef]
- Chaieb, K.; Hajlaoui, H.; Zmantar, T.; Kahla-Nakbi, A.B.; Rouabhia, M.; Mahdouani, K.; Bakhrouf, A. The chemical composition and biological activity of clove essential oil, Eugenia caryophyllata (Syzigium aromaticum L. Myrtaceae): A short review. Phytother. Res. 2007, 21, 501–506. [Google Scholar] [CrossRef] [PubMed]
- Zemek, J.; Košíková, B.; Augustin, J.; Joniak, D. Antibiotic properties of lignin components. Folia Microbiol. 1979, 24, 483–486. [Google Scholar] [CrossRef]
- Himejima, M.; Kubo, I. Antimicrobial agents from licaria puchuri-major and their synergistic effect with polygodial. J. Nat. Prod. 1992, 55, 620–625. [Google Scholar] [CrossRef] [PubMed]
- Kubo, I.; Muroi, H.; Himejima, M. Combination effects of antifungal nagilactones against candida albicans and two other fungi with phenylpropanoids. J. Nat. Prod. 1993, 56, 220–226. [Google Scholar] [CrossRef]
- Fujita, K.I.; Kubo, I. Potentiation of fungicidal activities of trans-anethole against saccharomyces cerevisiae under hypoxic conditions. J. Biosci. Bioeng. 2004, 98, 490–492. [Google Scholar] [CrossRef]
- De Jesus Faria, T.; Ferreira, R.S.; Yassumoto, L.; De Souza, J.R.P.; Ishikawa, N.K.; De Melo Barbosa, A. Antifungal activity of essential oil isolated from Ocimum gratissimum L. (eugenol chemotype) against phytopathogenic fungi. Braz. Arch. Biol. Technol. 2006, 49, 867–871. [Google Scholar] [CrossRef]
- Campaniello, D.; Corbo, M.R.; Sinigaglia, M. Antifungal Activity of Eugenol against Penicillium, Aspergillus, and Fusarium Species. J. Food Prot. 2010, 73, 1124–1128. [Google Scholar] [CrossRef]
- Carrasco, H.; Raimondi, M.; Svetaz, L.; Di Liberto, M.; Rodriguez, M.V.; Espinoza, L.; Madrid, A.; Zacchino, S. Antifungal activity of eugenol analogues. Influence of different substituents and studies on mechanism of action. Molecules 2012, 17, 1002–1024. [Google Scholar] [CrossRef]
- Amiri, A.; Dugas, R.; Pichot, A.L.; Bompeix, G. In vitro and in vitro activity of eugenol oil (Eugenia caryophylata) against four important postharvest apple pathogens. Int. J. Food Microbiol. 2008, 126, 13–19. [Google Scholar] [CrossRef] [PubMed]
- Wang, C.; Zhang, J.; Chen, H.; Fan, Y.; Shi, Z. Antifungal activity of eugenol against Botrytis cinerea. Trop. Plant Pathol. 2010, 35, 137–143. [Google Scholar] [CrossRef]
- Pal, C.; Bandyopadhyay, U. Redox-Active Antiparasitic Drugs. Antioxid. Redox Signal. 2012, 17, 555–582. [Google Scholar] [CrossRef] [PubMed]
- Siegmund, U.; Viefhues, A. Reactive Oxygen Species in the Botrytis—Host Interaction. In Botrytis—The Fungus, the Pathogen and its Management in Agricultural Systems; Fillinger, S., Elad, Y., Eds.; Springer: Berlin/Heidelberg, Germany, 2016; pp. 268–289. [Google Scholar]
- Martindale, J.L.; Holbrook, N.J. Cellular response to oxidative stress: Signaling for suicide and survival. J. Cell. Physiol. 2002, 192, 1–15. [Google Scholar] [CrossRef]
- Gill, A.O.; Holley, R.A. Mechanisms of bactericidal action of cinnamaldehyde against Listeria monocytogenes and of eugenol against L. monocytogenes and Lactobacillus sakei. Appl. Environ. Microbiol. 2004, 70, 5750–5755. [Google Scholar] [CrossRef] [PubMed]
- Ntamila, M.S.; Hassanali, A. Isolation of oil of clove and separation of eugenol and acetyl eugenol: An instructive experiment for beginning chemistry undergraduates. J. Chem. Ed. 1976, 53, 263. [Google Scholar] [CrossRef]
- Carrasco, H.; Robles-Kelly, C.; Rubio, J.; Olea, A.F.; Martínez, R.; Silva-Moreno, E. Antifungal effect of polygodial on Botrytis cinerea, a fungal pathogen affecting table grapes. Int. J. Mol. Sci. 2017, 18, 2251. [Google Scholar] [CrossRef]
- Leroch, M.; Kretschmer, M.; Hahn, M. Fungicide resistance phenotypes of botrytis cinerea isolates from commercial vineyards in South West Germany. J. Phytopathol. 2011, 159, 63–65. [Google Scholar] [CrossRef]
- Leroux, P.; Chapeland, F.; Desbrosses, D.; Gredt, M. Patterns of cross-resistance to fungicides in Botryotinia fuckeliana (Botrytis cinerea) isolates from French vineyards. Crop Prot. 1999, 18, 687–697. [Google Scholar] [CrossRef]
- Robles-Kelly, C.; Rubio, J.; Thomas, M.; Sedan, C.; Martinez, R.; Olea, A.F.; Carrasco, H.; Taborga, L.; Silva-Moreno, E. Effect of drimenol and synthetic derivatives on growth and germination of Botrytis cinerea: Evaluation of possible mechanism of action. Pestic. Biochem. Physiol. 2017, 141, 50–56. [Google Scholar] [CrossRef] [PubMed]
- Kelts, J.L.; Cali, J.J.; Duellman, S.J.; Shultz, J. Altered cytotoxicity of ROS-inducing compounds by sodium pyruvate in cell culture medium depends on the location of ROS generation. Springerplus 2015, 4, 269. [Google Scholar] [CrossRef] [PubMed]
- Scott, G.K.; Atsriku, C.; Kaminker, P.; Held, J.; Gibson, B.; Baldwin, M.A.; Benz, C.C. Vitamin K3 (menadione)-induced oncosis associated with keratin 8 phosphorylation and histone H3 arylation. Mol. Pharmacol. 2005, 68, 606–615. [Google Scholar] [CrossRef] [PubMed]
Sample Availability: Samples of the compounds 8–13 are available from the authors. |

| Eugenol Derivatives (from Figure 2) | IC50 (ppm) |
|---|---|
| 1 | 149 |
| 4 | 109 |
| 5 | 95 |
| 6 | 80 |
| 7 | 62 |
| 8 | I* |
| 9 | 440 |
| 10 | 221 |
| 11 | 45 |
| 12 | D* |
| 13 | 103 |
| 14 | 31 |
| 15 | 39 |
| 16 | 108 |
| 17 | 311 |
| BC-1000 (positive control) | 140 |
© 2019 by the authors. Licensee MDPI, Basel, Switzerland. This article is an open access article distributed under the terms and conditions of the Creative Commons Attribution (CC BY) license (http://creativecommons.org/licenses/by/4.0/).
Share and Cite
Olea, A.F.; Bravo, A.; Martínez, R.; Thomas, M.; Sedan, C.; Espinoza, L.; Zambrano, E.; Carvajal, D.; Silva-Moreno, E.; Carrasco, H. Antifungal Activity of Eugenol Derivatives against Botrytis Cinerea. Molecules 2019, 24, 1239. https://doi.org/10.3390/molecules24071239
Olea AF, Bravo A, Martínez R, Thomas M, Sedan C, Espinoza L, Zambrano E, Carvajal D, Silva-Moreno E, Carrasco H. Antifungal Activity of Eugenol Derivatives against Botrytis Cinerea. Molecules. 2019; 24(7):1239. https://doi.org/10.3390/molecules24071239
Chicago/Turabian StyleOlea, Andrés F., Angelica Bravo, Rolando Martínez, Mario Thomas, Claudia Sedan, Luis Espinoza, Elisabeth Zambrano, Denisse Carvajal, Evelyn Silva-Moreno, and Héctor Carrasco. 2019. "Antifungal Activity of Eugenol Derivatives against Botrytis Cinerea" Molecules 24, no. 7: 1239. https://doi.org/10.3390/molecules24071239
APA StyleOlea, A. F., Bravo, A., Martínez, R., Thomas, M., Sedan, C., Espinoza, L., Zambrano, E., Carvajal, D., Silva-Moreno, E., & Carrasco, H. (2019). Antifungal Activity of Eugenol Derivatives against Botrytis Cinerea. Molecules, 24(7), 1239. https://doi.org/10.3390/molecules24071239








